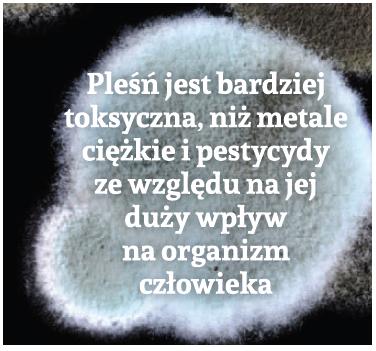

Pleśń jest żywym organizmem należącym do królestwa grzybów. Jest to znany alergen, zdolny wywołać poważne problemy zdrowotne u osób podatnych na jej działanie. Grzyby pleśniowe same nie produkują substancji odżywczych, dlatego muszą pozyskać je z rozkładu resztek organicznych lub atakując i trawiąc inne organizmy żywe. Za pomocą enzymów uwalnianych do i trawiących zaatakowanego gospodarza czy żywność rozbijają ją na małe i łatwo przyswajalne cząsteczki. Niektóre gatunki pleśni mają barwniki wewnętrzne, co nadaje im charakterystyczne kolory. Pleśń rośnie w postaci nitkowatych włókien, zwanych strzępkami, co nadaje jej owłosiony wygląd. Strzępki mogą być dość długie,tworzą szybko rosnące wypustki, co umożliwia pleśni atakowanie nowego miejsca i rozprzestrzenianie się z małej plamki w wielką kolonię.
Pleśń rozwija się jedynie w sprzyjających warunkach, czyli na pokarmach, które może trawić przy odpowiedniej wilgoci oraz temperaturze, wówczas także może wytwarzać i rozsiewać dookoła swoje zarodniki. Pleśń będzie atakować i rozwijać się na każdej materii organicznej zawierającej atomy węgla, zarówno wewnątrz jak i na zewnątrz budynków, przez co jest trudna do zwalczania. Walkę z pleśnią utrudnia też fakt, że istnieją dziesiątki tysięcy gatunków pleśni. Pleśń może rozwijać się w każdej temperaturze powyżej temperatury zamarzania wody, aczkolwiek preferuje ciepło. Obecność wilgoci zapewnia optymalne warunki zarówno dla rozmnażania, jak i kolonizacji pleśni. Z tego właśnie względu, pleśń jest wszechobecna w środowisku człowieka. Te cztery warunki sprawiają, że zwalczenie pleśni jest prawie niemożliwe. Jednak pamiętanie o tych czterech czynnikach i odpowiednie postępowanie może znacznie zmniejszyć ryzyko rozwoju pleśni w naszych domach i jej szkodliwe następstwa zdrowotne.
Istnieje około 100 000 znanych gatunków grzybów oraz prawdopodobnie drugie tyle jeszcze nieodkrytych. Niektóre są nie tylko jadalne, ale nawet bardzo smaczne, jak na przykład pieczarki czy też pożyteczne, jak drożdże, stosowane chociażby w procesie pieczenia pieczywa, czy fermentacji napojów alkoholowych, takich jak wino i piwo. Chociaż niektóre gatunki pleśni mogą powodować poważne choroby, o ironio, Alexander Fleming odkrył, jak zrobić pierwszy leczniczy antybiotyk z pleśni Penicillium (stąd nazwa penicylina)! Większość gatunków pleśni, produkuje różnego rodzaju mykotoksyny (toksyny grzybicze), które można znaleźć w zaatakowanej paszy, ziarnie, czy też żywności przeznaczonej dla ludzi. Najczęściej spotykane to: aflatoksyny (istnieje kilka podklas, takich jak B1, B2, G1 i G2). Aflatoksyny powszechnie występują w ziarnach, takich jak kukurydza, a także w płatkach zbożowych zjadanych zarówno przez dorosłych, jak i dzieci! Inną znaną mykotoksyną jest patulina, którą można znaleźć w gnijących jabłkach, owocach, warzywach i ziarnach. Jeszcze innymi są fumonizyna, często znajdywana w kukurydzy, czy trichotecyna, którą znajdziemy w pszenicy, kukurydzy oraz owsie. Z kolei ochratoksyna A występuje w kawie, suszonych owocach, czerwonym winie oraz we wspomnianych płatkach zbożowych. Pleśń może rozwijać się zarówno w gotowanej, jak i niegotowanej żywności, w szczególności w długo przechowywanej, lub która nie była przechowywana w niskich temperaturach, hamujących rozwój pleśni. Nieodpowiednie przechowywanie sprzyja produkcji różnych rodzajów mykotoksyn i wzrostu ich zawartości w żywności.
Mykotoksyny są dobrze rozpoznanymi alergenami, wnikającymi i kumulującymi się na przykład w drogach oddechowych, powodując ich podrażnienie, stany zapalne i prowadząc do uwolnienia z komórek histaminy, czyli substancji chemicznej odpowiedzialnej za reakcję alergiczną. Jest ona częściowo odpowiedzialna za objawy zapalenia, a także zwężenie dróg oddechowych (oskrzeli) w płucach, i objawy z tym związane, jak np. sapanie i duszność, szczególnie u osób z astmą, przewlekłą obturacyjną chorobą płuc (POChP) lub rozedmą płuc. Główne objawy tych chorób to świszczący oddech i duszność. U osób wrażliwych, reakcje alergiczne mogą wystąpić natychmiast lub chwilę po ekspozycji na bodźce powodujące atak astmy lub poważne infekcje u osób z osłabionym systemem immunologicznym lub przewlekłą chorobą płuc. Nasilenie reakcji alergicznej jest u tych osób w znacznym stopniu zależne od stopnia ekspozycji na pleśń.
Wszechobecność zarodników pleśni w powietrzu i w naszych domach, miejscach pracy, szkołach, łazience, a zwłaszcza w kuchni znacznie zwiększa prawdopodobieństwo wystąpienia objawów alergicznych. Pierwsze objawy wystąpienia alergii spowodowanej pleśnią, nawet u osób bez upośledzenia funkcji układu oddechowego, to swędzenie i zaczerwienie oczu, przewlekły kaszel, migreny, bóle głowy, skurcze mięśni, drętwienie i mrowienie. Inne symptomy to wysypka, silne łzawienie oczu, zmęczenie, zablokowany nos, osłabienie pamięci, zmienne nastroje, depresja, ataki paniki, spowolnione myślenie, uczucie zagubienia, bezsenność oraz arytmia serca.
Co z tymi, którzy nie są uczuleni na działanie pleśni, czy również powinni zachować ostrożność? Uważa się, że pleśń jest bardziej toksyczna, niż metale ciężkie i pestycydy ze względu na jej duży wpływ na organizm człowieka, m.in. na układ moczowy, co przejawia się uszkodzeniem nerek, czy też naukład pokarmowy w postaci martwicy komórek wątrobowych, prowadzącej do uszkodzenia wątroby, jej zwłóknienia i bliznowacenia. W układzie pokarmowych obserwuje sięczęsto przewlekłe biegunki, czy też zgagę i wymioty. Pleśń wpływa uszkadzająco także na układ naczyniowy. Podnosi poziom plazminogenu, przez co nasila stany zapalne ściany naczyń krwionośnych. Naczynia stają się kruche, co powoduje mniejsze lub większe krwawienia do tkanek. Pleśniom przypisywany jest także szkodliwy wpływ na system nerwowy, powodując utratę koordynacji, bóle głowy, niepokój, stwardnienie rozsiane, drgawki a nawet obniżenie ilorazu inteligencji (IQ) u dzieci, co wykazały m.in. badania inteligencji wśród sześciolatków z Krakowa, wystawionych na działanie pleśni. Badania te zostały przeprowadzone przez Jędrychowskiego w 2011 roku. Układ rozrodczy z kolei narażony jest na zaburzenia cyklu miesięcznego u kobiet i bezpłodność. System immunologiczny natomiast, jest osłabiony, co prowadzi do immunosupresji (jego osłabienia). Największy narząd naszego ciała, czyli skóra jest także podatny na działanie pleśni, co może objawiać się jej nadwrażliwością, uczuciem pieczenia lub wysypką. Stąd, im mniejszy nasz kontakt z mykotoksynami, tym lepiej, niezależnie od naszej wrażliwości.
Globalizacja i ciągły nacisk na wolny handel na całym świecie, a w ślad za tym subtelne, ale stałe zmiany w nawykach żywieniowych sprawiają, że o wiele łatwiej jest narazić się na działanie pleśni, co pokazało np. badanie 237 rodzajów płatków śniadaniowych w Pakistanie. Płatki te zostały zbadane pod względem zawartości różnych rodzajów mykotoksyn. W 41% z nich stwierdzono występowanie aflatoksyn (AF), z czego 8 % z nich przekraczało dozwolony przez Unię Europejską maksymalny dopuszczalny poziom. Dodatkowo, u 53 % wykryto zearalenon (ZEA), również o 8% wykraczający poza normy Unii Europejskiej. ZEA jest to mykotoksyną występującą w zbożach, takich jak owies, jęczmień, ryż, kukurydza, sorgo, a także w piwie, drobiu i mięsie pochodzącym od zwierząt karmionych suchymi paszami zbożowymi. ZEA znana jest z tego, że zakłóca działanie estrogenu (żeńskiego hormonu płciowego).

Mówią o tym m.in. wyniki badania przeprowadzonego w New Jersey w Stanach Zjednoczonych w 2011 roku pod kątem zawartości ZEA w moczu dziewczynek w wieku 9-10 lat. Stwierdzono wówczas, że u 78,5% badanych występują mykotoksyny ZEA, a także pozytywny związek pomiędzy poziomem ZEA w moczu, a częstotliwością spożycia produktów żywnościowych będących źródłem ZEA, takich jak popcorn i wołowina pochodząca od zwierząt karmionych paszą. Stwierdzono również, że dziewczęta te są niższego wzrostu oraz później rozwijają się u nich gruczoły piersiowe. Natomiast, w innym badaniu przeprowadzonym w Ankarze w Turcji, odkryto aflatoksynę typu M(1) i B(1) w próbkach mleka od kobiet karmiących piersią. Tamtejsza populacja słynie z wysokiej konsumpcji zboża. Zmierzone w mleku stężenia aflatoksyny M i B odpowiednio zawarły się w zakresie od 61-300 ng/L (dopuszczalny poziom <215 ng/L) oraz 94-4124 (dopuszczalny poziom < 269 ng/L). Pokazuje to, w jakim stopniu kobiety narażone są na działanie aflatoksyn zawartych w jedzeniu, oraz nieświadomie szkodzą swoim noworodkom przyjmującym te toksyny z ich naturalnym mlekiem. W badaniu in vitro przeprowadzonym w Argentynie, kraju, który jest jednym z największych eksporterów kukurydzy na świecie, odkryto, że glifosat będący podstawowym herbicydem stosowanym w uprawie genetycznie modyfikowanej (GMO) kukurydzy, powoduje szybszy wzrost pleśni produkujących mykotoksyny AF B1 na kolbach kukurydzy i wewnątrzziaren. Dla ludzi mykotoksyna AF B1 została uznana przez Międzynarodową Agencję Badań nad Rakiem (IARC),jako substancja rakotwórcza grupy 1. Aflatoksyna jest obecnieuznawana za główną przyczynę raka wątrobowokomórkowego (hepatocarcinoma), jednego z najzłośliwszych nowotworów człowieka.
Chcąc zmniejszyć swój kontakt z pleśnią, należy unikać spożywania źle przechowywanych i przetworzonych ziaren oraz produktów z nich robionych lub znacznie zmniejszyć ich konsumpcję. Nasz węch nie jest wystarczająco czuły, aby wyczuć zapach pleśni w ziarnach i mące, a zatem makaron,płatki, brązowy ryż a także pełnoziarniste produkty ze swoim oleistym wnętrzem mogą być źródłem pleśni. Chleb lub inne wypieki zapakowane w plastik zachowują wilgoć, co rozpoczyna proces rozwijania się pleśni. To z kolei wiąże się z dodawaniem substancji hamujących ten proces już w samym cieście używanym do wypieku pieczywa. Zatem, należy unikać wypieków z długim terminem przydatności do spożycia, gdyż mają one więcej pleśni, a tym samym mykotoksyn. W przypadku osób wrażliwych na działanie pleśni, czyli np. astmatyków, ważne jest, aby unikać żywności, która zazwyczaj zawiera pleśń, np. suszonych owoców, koncentratu pomidorowego, przetworów mięsnych, czarnej herbaty, sosu sojowego, komercyjnych soków owocowych, serów pleśniowych, likierów, ciemnego piwa, brązowego ryżu oraz nadmiernie dojrzałych owoców i warzyw. Ważne także jest ograniczanie rozwoju pleśni w naszych domach. Można to zrobić dbając o odpowiednią wentylację w łazience, tak aby wilgoć tam występująca była na jak najniższym poziomie. Wszelkie wycieki wody powinny być szybko naprawiane. W całym domu musi być zapewniona wentylacja pomieszczeń oraz należy je regularnie wietrzyć. Natomiast, jeśli pleśń rozwinęła się na jakichś artykułach gospodarstwa domowego, żywności, czy odzieży, należy natychmiast się tych rzeczy pozbyć. Zdrowie Twoje i Twoich bliskich ma większą wartość.
W ograniczaniu rozwoju pleśni i to nie tylko w przypadku astmatyków, należy pamiętać o witaminie D3. Witamina ta poprawiając naszą odporność immunologiczną zmniejsza podatność na mykotoksyny pleśni Aspergillus fumigatus, które są powszechnie spotykane w naszych domach. Dla większości zdrowych ludzi są one na ogół nieszkodliwe, ale mogą być bardzo niebezpieczne dla osób cierpiących na astmę, choroby płuc i osłabienie systemu immunologicznego. Wykazano w badaniach, że zadbanie o odpowiednio wysokie stężenie witaminy D we krwi, jest kwestią kluczową dla produkcji w naszym organizmie ponad 200 własnych mikrobójczych peptydów, zwanych czasami naturalnymi antybiotykami, takich jak np. defensyny, katelicydyny. My sami je produkujemy do zwalczania infekcji wirusowych, bakteryjnych i grzybiczych. Zatem, z końcem zimy, gdy czekamy jeszcze na wiosnę i słońce, jest bardzo prawdopodobne, że stężenie witaminy D we krwi jest dość niskie. Warto zrobić sobie takie badanie krwi i w razie potrzeby rozpocząć suplementację witaminy D3, czekając na słońce i lato. Można też przyjechać po naturalną witaminę D w czasie polskiej zimy do słonecznej Kenii. U Nas jest Słońce cały rok. «Karibu Kenya”, co znaczy w moim języku „Zapraszam do Kenii”.

Dr Gitahi Theuri – specjalista w dziedzinie fizjologii i interwencyjnej profilaktyki chorób wynikających ze stylu życia przy użyciu niefarmakologicznych środków, służących do przywrócenia stanu zdrowia. Posiada 16 lat doświadczenia klinicznego, z czego 10 lat poświęcił kardiologii w Kenii. Ponadto zdobywał doświadczenie na wydziale kardiologicznym w Szpitalu Memorial w Maryland w Stanach Zjednoczonych. Studiował Żywienie Kliniczne w programie ASPEN na Uniwersytecie Maastricht w Holandii, Profilaktykę Cukrzycy oraz Chorób Układu Krążenia na Uniwersytecie w Kopenhadze w Danii. Opublikował ponad 10 streszczeń i wiele artykułów w magazynach dotyczącyh badań klinicznych. Prezentował wiele opracowań traktujących o niefarmakologicznych interwencjach w przypadku chorób związanych z układem krwionośnym i pokarmowym podczas międzynarodowych konferencji w Afryce, Europie i na Bliskim Wschodzie. Jego zakres zainteresowań, to: rola witaminy D i optymalizacja żywienia w zapobieganiu chorób przewlekłych, a także udoskonalanie równowagi hormonów płciowych. Jego praca doktorska skupiała się na biomarkerach chorób układu krążenia w kontekście życia na wsi i w mieście. Jest wykładowcą na wydziale Nauki Stosowanej na Uniwersytecie Kenyatta w Kenii, gdzie koordynuje prace w Laboratorium nad Wydolnością Człowieka, jednocześnie prowadząc ćwiczenia w laboratorium z zakresu metod żywienia, fizjologii stosowanej oraz z zakresu zarządzania chorobami przewlekłymi dzięki zastosowaniu ćwiczeń fizycznych. Jest promotorem żywności organicznej i produktów o wysokiej wartości odżywczej.
źródło: https://hipoalergiczni.pl/plesn-alergen-w-pelnym-tego-slowa-znaczeniu/
